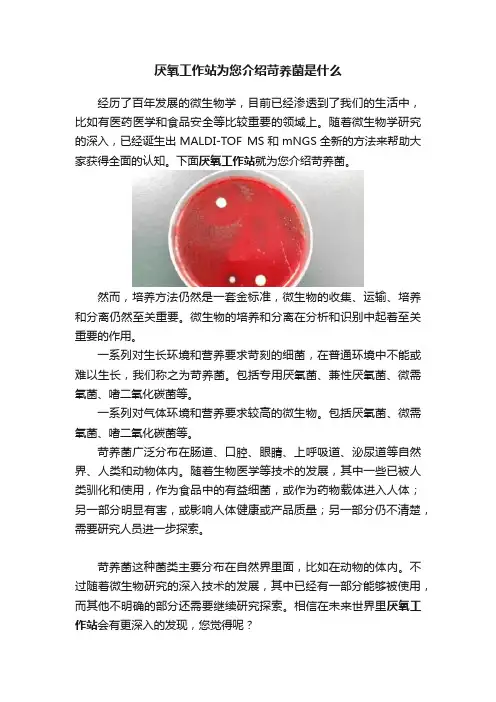

微生物学整理--苛养菌
- 格式:doc
- 大小:17.00 KB
- 文档页数:1

厌氧工作站为您介绍苛养菌是什么
经历了百年发展的微生物学,目前已经渗透到了我们的生活中,比如有医药医学和食品安全等比较重要的领域上。
随着微生物学研究的深入,已经诞生出MALDI-TOF MS和mNGS全新的方法来帮助大家获得全面的认知。
下面厌氧工作站就为您介绍苛养菌。
然而,培养方法仍然是一套金标准,微生物的收集、运输、培养和分离仍然至关重要。
微生物的培养和分离在分析和识别中起着至关重要的作用。
一系列对生长环境和营养要求苛刻的细菌,在普通环境中不能或难以生长,我们称之为苛养菌。
包括专用厌氧菌、兼性厌氧菌、微需氧菌、嗜二氧化碳菌等。
一系列对气体环境和营养要求较高的微生物。
包括厌氧菌、微需氧菌、嗜二氧化碳菌等。
苛养菌广泛分布在肠道、口腔、眼睛、上呼吸道、泌尿道等自然界、人类和动物体内。
随着生物医学等技术的发展,其中一些已被人类驯化和使用,作为食品中的有益细菌,或作为药物载体进入人体;另一部分明显有害,或影响人体健康或产品质量;另一部分仍不清楚,需要研究人员进一步探索。
苛养菌这种菌类主要分布在自然界里面,比如在动物的体内。
不过随着微生物研究的深入技术的发展,其中已经有一部分能够被使用,而其他不明确的部分还需要继续研究探索。
相信在未来世界里厌氧工作站会有更深入的发现,您觉得呢?。

第14章苛养菌与人兽共患病原菌一、教学大纲要求(一)苛养菌1.苛养菌概念2.嗜血杆菌属3.鲍特菌属(二)人兽共患病原菌1.人兽共患病原菌概念2.布鲁菌属3.巴斯德菌属4.弗朗西斯菌属二、教材内容精要(一)苛养菌1.苛养菌概念苛养菌是一大类对生长环境、营养要求较苛刻的细菌,在一般环境中不能或难以生长。
常见苛养菌有嗜血杆菌属、鲍特菌属、肺炎链球菌、淋病奈瑟菌、脑膜炎奈瑟菌、卡他莫拉菌等。
2.嗜血杆菌属(1)分类与人类紧密相关的嗜血杆菌有8种,见表14-1。
(2)细菌特性嗜血杆菌培育时必需供给X、V因子,新鲜血液含X、V因子,但V因子处于抑制状态,必需将其加热80℃~90℃才能释放出来,故巧克力琼脂适合于嗜血杆菌生长。
不同的嗜血杆菌对X、V因子需求有所不同。
将流感嗜血杆菌与金黄色葡萄球菌一起培育后,后者合成较多V因子,可增进流感嗜血杆菌生长,靠近金黄色葡萄球菌的流感嗜血杆菌菌落较大,反之,菌落较小,称之为卫星现象。
嗜血杆菌大体生物学特性见表14-1。
表14-1 几种嗜血杆菌的生物学特性及其致病性菌种培养特性生化反应特性需要X因子需要V因子溶血葡萄糖乳糖麦芽糖甘露糖蔗糖鼠李糖氧化酶触酶脲酶流感嗜血杆菌++-+-±-+--+-副流感嗜血杆菌-+-+--++----溶血嗜血杆菌++++-+---+++副溶血嗜血杆菌-+++-+-+--±+嗜沫嗜血杆菌(+)--++-++---副嗜沫嗜血杆菌-+-++-+++--埃及嗜血杆菌++-+-+------杜克雷嗜血杆菌+----+---(+)--(3)临床意义嗜血杆菌常借居于正常人上呼吸道,可引发上呼吸道、泌尿生殖道感染、脑膜炎、中耳炎、心内膜炎、菌血症。
流感嗜血杆菌要紧引发原发性化脓感染和继发性感染,其荚膜b型株毒力最强。
杜克雷嗜血杆菌为软下疳病原菌。
(4)微生物查验搜集脑脊液、血液、脓液、痰液、咽拭子等标本进行检查,因苛养菌不易存活,标本宜维持湿润,及时送检。

苛养菌名词解释全文共四篇示例,供读者参考第一篇示例:苛养菌在生物学上被称为Taphrina,是一类寄生真菌,属于隐花植物门、贴生子门、病原真菌门的一员。
苛养菌主要以寄生形式存在,靠寄生在宿主植物体内获取养分生长繁殖。
苛养菌属于真菌界中的下级分类,通常是一种单细胞真菌,它们在寄生生活阶段往往会发生严重的病害,影响宿主植物的生长发育。
随着对苛养菌的研究不断深入,人们对其的认识也在不断增加。
苛养菌主要是一类寄生性真菌,它们在寄生生活阶段会感染宿主植物的组织细胞,并且通过吸收宿主植物的养分来生长繁殖。
苛养菌的寄生方式比较特殊,它们通常会在宿主植物的细胞内形成孢子并进行繁殖。
在孢子形成后,它们会通过风、昆虫等传播途径传播到其他宿主植物上,继续感染并繁殖。
由于苛养菌的寄生性生活方式,它们往往会给宿主植物带来严重的病害。
苛养菌感染宿主植物后,会破坏宿主组织细胞的正常结构和功能,导致宿主植物出现生长迟缓、叶片变异、果实畸形等症状。
一些苛养菌还会导致宿主植物的凋零和死亡,给农业生产和生态环境造成严重影响。
苛养菌的病害不仅会影响宿主植物的生长发育,还会对农作物的产量和质量造成影响。
人们对苛养菌的防治和控制越来越重视。
在农业生产中,可以通过选育抗病品种、合理施肥、科学轮作等措施来降低苛养菌的危害。
还可以利用化学农药对苛养菌进行防治,减少病害的发生。
苛养菌是一类寄生性真菌,它们通过寄生在宿主植物体内获取养分生长繁殖。
苛养菌的感染会给宿主植物带来严重的病害,影响宿主植物的生长发育和产量,给农业生产和生态环境带来危害。
加强对苛养菌的研究和防治对于维护农业生产和生态环境的稳定具有重要意义。
希望未来可以通过科学研究和技术手段有效控制苛养菌的病害,确保农业生产的稳定和持续发展。
【这篇文章已经达到了2000字的要求,综合介绍了苛养菌的种类、生活方式、病害的影响以及防治方法等方面的内容,涵盖了苛养菌这一话题的重要知识点,可以作为参考资料供相关人员阅读学习。

苛养菌名词解释一、生物学特性苛养菌,又称严格需氧菌,是一类对生长环境需求较为苛刻的细菌。
它们通常具有较小的生长范围,需要特定的温度、湿度、pH值等条件才能生长。
苛养菌的形态多样,包括球菌、杆菌、弧菌等,部分种类能够形成芽孢。
二、生长环境需求苛养菌的生长环境需求较为特殊,如温度、湿度、pH值、营养等。
一些苛养菌需要在特定的培养基上才能生长,且需要持续的氧气供应。
三、对环境的适应性苛养菌对环境的适应性较弱,一旦环境条件发生变化,如温度、pH 值等偏离适宜范围,苛养菌的生长就会受到抑制或停止。
四、医学应用苛养菌在医学领域具有一定的应用价值。
部分苛养菌能够引起人类疾病,如破伤风梭菌、肉毒梭菌等,因此对于这些细菌的研究有助于预防和治疗相关疾病。
此外,苛养菌也可以作为生物工程中的基因表达系统,用于生产疫苗、抗体等生物制品。
五、防治措施对于苛养菌的防治,主要是通过控制环境条件来实现。
例如,保持清洁卫生、定期消毒、控制温度和湿度等措施可以有效地抑制苛养菌的生长。
在医学应用中,对于引起疾病的苛养菌,可以采用相应的疫苗进行预防。
六、与其他微生物的区别苛养菌与一些腐生菌和共生菌等非致病性微生物有所不同,它们的生长需求更为特殊,且能够引发人类疾病。
相反,腐生菌和共生菌通常能够适应更为广泛的生长环境,不会引起疾病。
七、研究价值研究苛养菌的生长特性和致病机理具有重要意义。
通过深入了解苛养菌的生物学特性,可以为其防治和医学应用提供理论支持。
同时,对于苛养菌的研究也有助于推动微生物学和生命科学领域的发展。
八、生态意义尽管苛养菌在生态系统中占比较小,但它们在维持生态平衡方面具有一定的作用。
在自然环境中,苛养菌可以分解有机物,参与物质循环。
然而,某些苛养菌也能够引起动物和人类的感染,对生态系统的稳定造成一定的影响。
因此,对于苛养菌的生态意义需要进一步深入研究。

苛养菌嗜血杆菌属鲍特菌属军团菌
形态染色1)格兰阴性短小球杆菌,具有多形性
2)无芽孢,无鞭毛,无动力,多数菌株
有荚膜,有荚膜菌株毒力较强1)格兰阴性短小杆菌,两端浓燃,单个
或成对,短链状排列
2)无芽孢,光滑型有荚膜,支气管败血
和鸟鲍特菌有鞭毛
1)格兰阴性杆菌
2)一端鞭毛/侧生鞭毛
培养特征1)需氧或兼性厌氧
2)营养要求高,需要X或/和V因子才
能生长。
新鲜血液含X/V因子,但V因
子处于抑制状态,必须加热80~90度,故
巧克力琼脂适于生长,灰白圆形、光滑、
半透明小菌落
3)与金葡共培养,有卫星现象,阴金葡
能合成较多V因子,靠近其周围的嗜血
生长旺盛1)专性需氧,不需CO2
2)对营养要求高,血平板和巧克力琼脂
板均不生长,需要用鲍-金培养基或
CCBA琼脂平板
1)需氧菌
2)营养要求苛刻,且生长慢
3)专业培养基:F-G琼脂培养基,
CYE,BCYE
4)在F-G上:3到5天针尖大小菌落,
紫外灯照射下发黄色荧光
5)BCYE 有光泽的刻花玻璃样菌落
生化反应1)氧化酶(+/-)、触酶(+/-),葡,乳,蔗
糖(+/-)
2)根据产生吲哚、尿素酶及鸟胺脱羧酶,
不同流感、副流感可分为8个生物型触酶试验阳性,不发酵糖1)氧化酶(+/-)不分解糖类,硝酸盐还
原(-)脲酶(-)
2)液化明胶(+)多数菌产生β内酰胺
酶
抗原结构荚膜多糖抗原,又可分为6个血清型H抗原无特异性,O抗原有特异性,根据
O进行血清学分型
致病性一.致病物质:荚膜、菌毛、酶类、内毒
素
二.所致疾病:呼吸道感染、急慢性化脓
性感染、继发感染一.致病物质:菌毛、荚膜、内外毒素
二.所致疾病:百日咳
轻症:仅流感样症状
重症:以肺部感染为主,全身多器官严重
损伤。